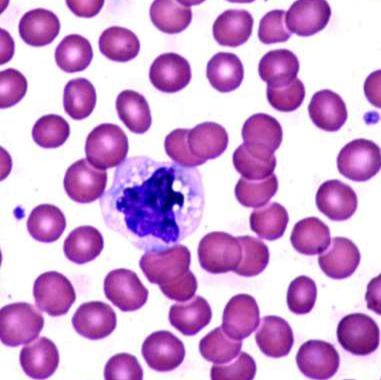
产品封面图

相关产品推荐更多 >
万千商家帮你免费找货
0 人在求购买到急需产品
- 详细信息
- 询价记录
- 文献和实验
- 技术资料
- 供应商:
ATCC
- 细胞类型:
原代细胞
- ATCC Number:
PCS-800-011
- 物种来源:
Homo sapiens, human
- 细胞形态:
spherical; variable after culturing
- 是否是肿瘤细胞:
否
- 器官来源:
Blood
- 运输方式:
干冰运输
- 生长状态:
悬浮
- 英文名:
Primary Peripheral Blood Mononuclear Cells (PBMC), Normal, Human
- 规格:
1ml/支
| 物种 | Homo sapiens, human |
| 组织 | Blood |
| 产品形式 | frozen 1 mL |
| 产品类型 | Primary cell 原代细胞 |
| 形态 | spherical; variable after culturing |
| 生长状态 | Suspension, variable after culturing |
| 性别 | Lot-specific |
| 原始寄存单位评语 | Peripheral blood mononuclear cells (PBMC) have a limited lifespan in culture and should only be thawed immediately prior to their intended use. ATCC does not recommend maintaining peripheral blood mononuclear cells in culture in the absence of application-specific growth factors. Peripheral blood mononuclear cells are a heterogeneous population of blood cells with a single round nucleus and include macrophages, dendritic cells, monocytes and lymphocytes. |
| 应用 | 3D cell culture Immunology Toxicology Immuno-oncology Cell and gene therapy (CGT) development |
| 存储条件 | Vapor phase of liquid nitrogen |
| 科研用途 | This product is intended for laboratory research use only. It is not intended for any animal or human therapeutic use, any human or animal consumption, or any diagnostic use. |
| 生物安全等级 | BSL 1 ATCC determines the biosafety level of a material based on our risk assessment as guided by the current edition of Biosafety in Microbiological and Biomedical Laboratories (BMBL), U.S. Department of Health and Human Services. It is your responsibility to understand the hazards associated with the material per your organization’s policies and procedures as well as any other applicable regulations as enforced by your local or national agencies. ATCC highly recommends that appropriate personal protective equipment is always used when handling vials. For cultures that require storage in liquid nitrogen, it is important to note that some vials may leak when submersed in liquid nitrogen and will slowly fill with liquid nitrogen. Upon thawing, the conversion of the liquid nitrogen back to its gas phase may result in the vial exploding or blowing off its cap with dangerous force creating flying debris. Unless necessary, ATCC recommends that these cultures be stored in the vapor phase of liquid nitrogen rather than submersed in liquid nitrogen. |
风险提示:丁香通仅作为第三方平台,为商家信息发布提供平台空间。用户咨询产品时请注意保护个人信息及财产安全,合理判断,谨慎选购商品,商家和用户对交易行为负责。对于医疗器械类产品,请先查证核实企业经营资质和医疗器械产品注册证情况。
- 作者
- 内容
- 询问日期
文献和实验Aboul‐Enein M N, et al. Design, Synthesis, and Cytotoxic Evaluation of Certain 7‐Chloro‐4‐(piperazin‐1‐yl) quinoline Derivatives as VEGFR‐II Inhibitors. Arch Pharm Weinheim 350: 3-4, 2017. PubMed: 28304102
Hou W, et al. Determination of the Cell Permissiveness Spectrum, Mode of RNA Replication, and RNA-Protein Interaction of Zika Virus. BMC Infect Disease, 17(1):239, 2017. PubMed: 28359304
Mohamed, M, et al. Cytotoxicity And Anti-Cancer Effect Of Mangrove Crab (Scylla Serrata) Soup On Human Leukemic Jurkat Cells. Eur J Pharma Med Res 4(2): 192-195, 2017.
Li, X et al. Brain Natriuretic Peptide-Regulated Expression of Inflammatory Cytokines in Lipopolysaccharide (LPS)-Activated Macrophages Via NF-kB and Mitogen Activated Protein Kinase (MAPK) Pathways. Med Sci Monit, 24: 3119-3126, 2018. PubMed: 29754152
Kim Wiese, A, et al. DNA-PKcs Controls Calcineurin Mediated IL-2 Production in T Lymphocytes. PloS One, 12(7):e0181608, 2017. PubMed: 28750002
人外周血PBMC的制备流程 收集抗凝人外周血,用 1640 无血清培养基或 PBS 按照 1:1 的比例稀释,上下颠倒混匀或者用移液枪吹打混匀。 在 15 mL 离心管中,先加入 3 mL 充分混匀的 Ficoll 液(1.077 g/mL),再沿着管壁缓慢加入2 mL稀释后的血液,血液和 Ficoll 液分层明显为成功。 注:Ficoll 提前半小时从 4℃ 冰箱取出恢复到室温,温度过高会导致分离不明显,温度过低会导致密度过大,同样分离效果不好, 20~25℃ 最佳。。 将样本小心转移
外周血单个核细胞(Peripheral Blood Mononuclear Cell,PBMC),是指外周血中具有单个核的细胞,包括淋巴细胞(Lymphocyte)、单核细胞(Monocyte)、树突状细胞(DC)和其他少量细胞。 1 原理 单个核细胞的体积、形态和比重与外周血其它细胞不同,红细胞和多核白细胞的比重超过1.080,单个核细胞的比重为1.070左右,血小板为1.030左右。因此,可利用各种血细胞和单个核细胞比重之间的差异将各种血细胞与单个
流式课堂 | 裂红 or 分离液?外周血不同制备方法应用场景
,会丢失一部分稀有细胞 ⊙ 可能会引起细胞受体激活 分离前 总 结 • 如研究对象是淋巴细胞、单核细胞或粒细胞,且细胞不需要进行培养或冻存,仅进行流式分析时,建议使用裂红法制备外周血样本; • 如研究对象是淋巴细胞亚群或单核细胞,在做以下实验时,建议使用 Ficoll 法提取 PBMC: (1)获得的细胞需要继续培养、刺激、阻断或冻存; (2)研究单核细胞。因为单核细胞只占白细胞的 3-10%,如果使用裂红法,会发现细胞群体太少。为了保证充足的样本量,需要使用 Ficoll 法。
技术资料暂无技术资料 索取技术资料